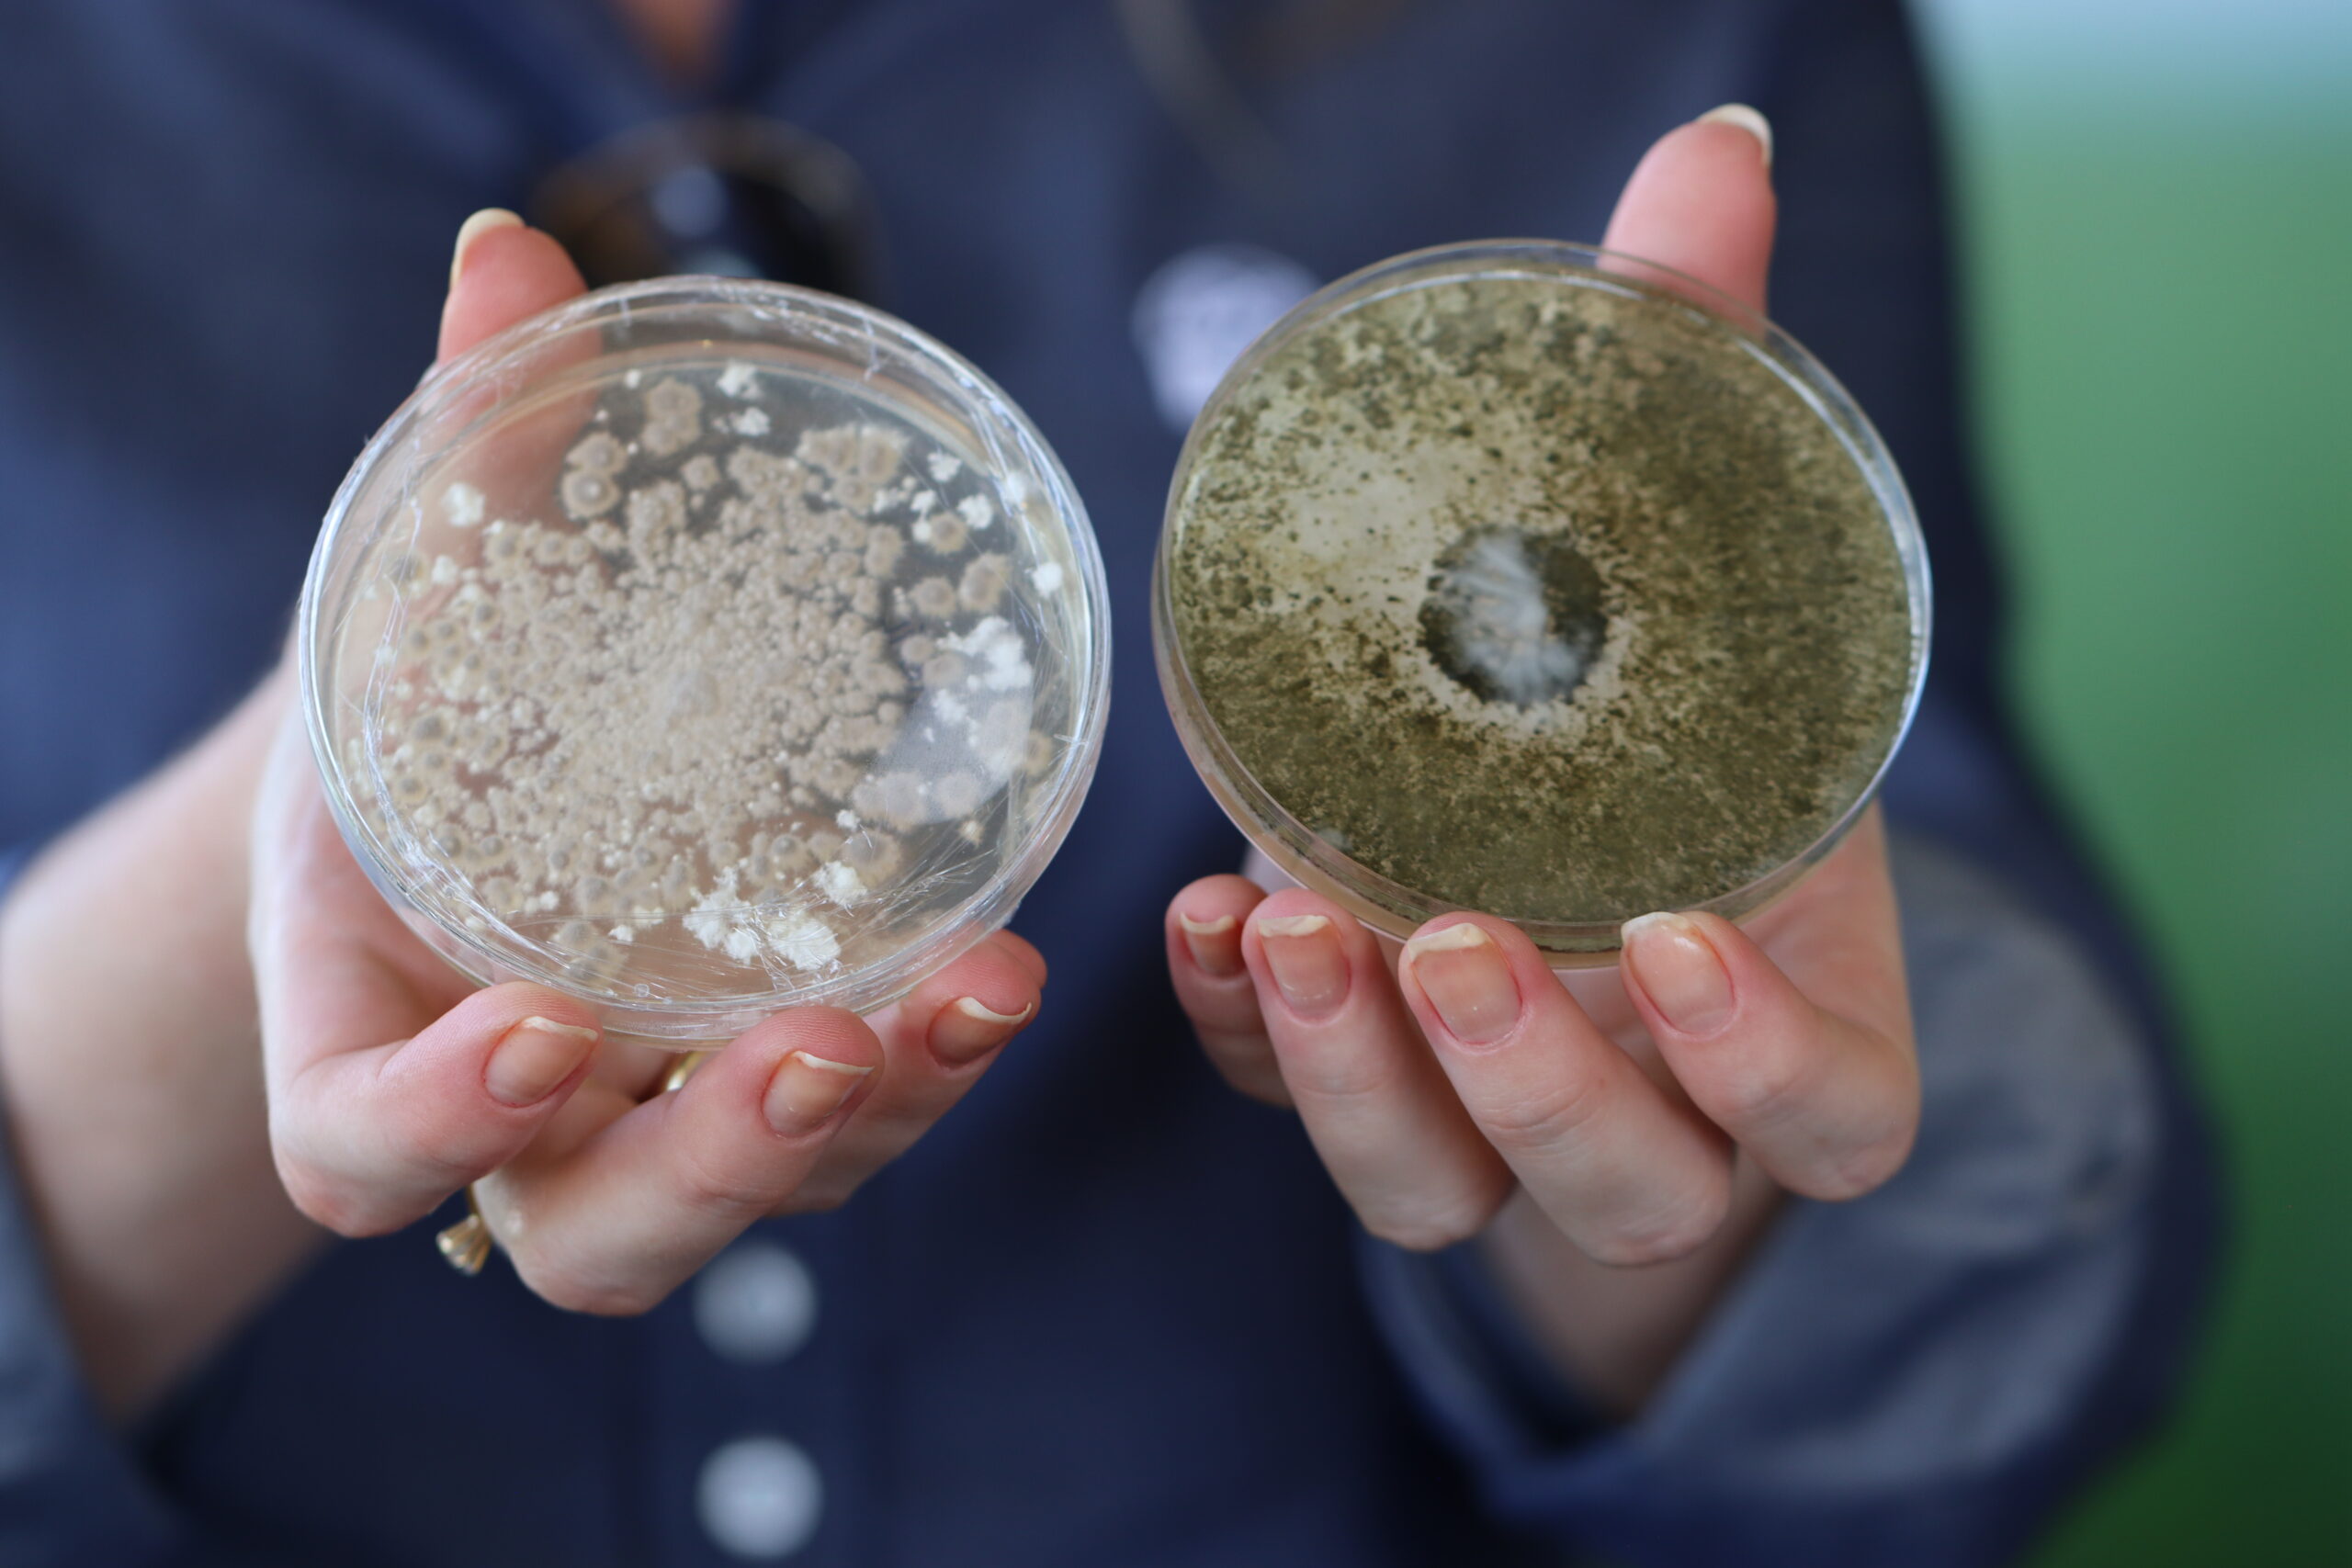

Conectando produtores, parceiros e soluções
Dia de Campo I.Riedi
Evento técnico anual pensado exclusivamente para o produtor rural, adaptado às diferentes realidades do campo. Um espaço para vivenciar tecnologias, práticas e resultados, trocar experiências e conhecer soluções inovadoras que transformam conhecimento em decisões eficazes e mais produtividade.
2026
Dia de Campo – Toledo
Garanta sua vaga para a próxima edição e veja, no campo, as tecnologias que estão dando resultado.
- 15 a 17 de janeiro de 2026
Aprendizado que nasce no solo
Como foram as últimas edições
Confira os destaques técnicos, fotos e aprendizados das edições anteriores, vitrines e decisões que viraram resultado.
2026
A edição de 2026 renova a importância de um olhar atento à proteção de cultivos e às janelas de aplicação ideais. O evento foi um termômetro para o planejamento da safra pois apresentou comparativos rigorosos de tecnologia agrícola. As fotos mostram a participação massiva dos produtores em busca de soluções inovadoras para reduzir riscos e maximizar a rentabilidade no campo.
- 05 a 07 de janeiro
2025
A edição de 2025 reafirmou o compromisso da I.RIEDI com a produtividade sustentável. O destaque ficou para as novas vitrines tecnológicas de híbridos e cultivares, apresentando resultados práticos de manejo, nutrição avançada e tratamento de sementes. Um encontro marcado pela troca de conhecimento estratégico entre especialistas e produtores que buscam o próximo nível na lavoura.
- 07 a 09 de janeiro
2024
A edição de 2024 teve seu foco no desempenho das culturas de soja e milho nas condições climáticas do Oeste paranaense. Com estações dinâmicas de manejo integrado e análises de eficiência nutricional, o evento proporcionou uma compreensão maior das tecnologias mais atuais do setor, e fortaleceu a rede de contatos entre quem vive o agro no dia a dia.
- 09 a 11 de janeiro